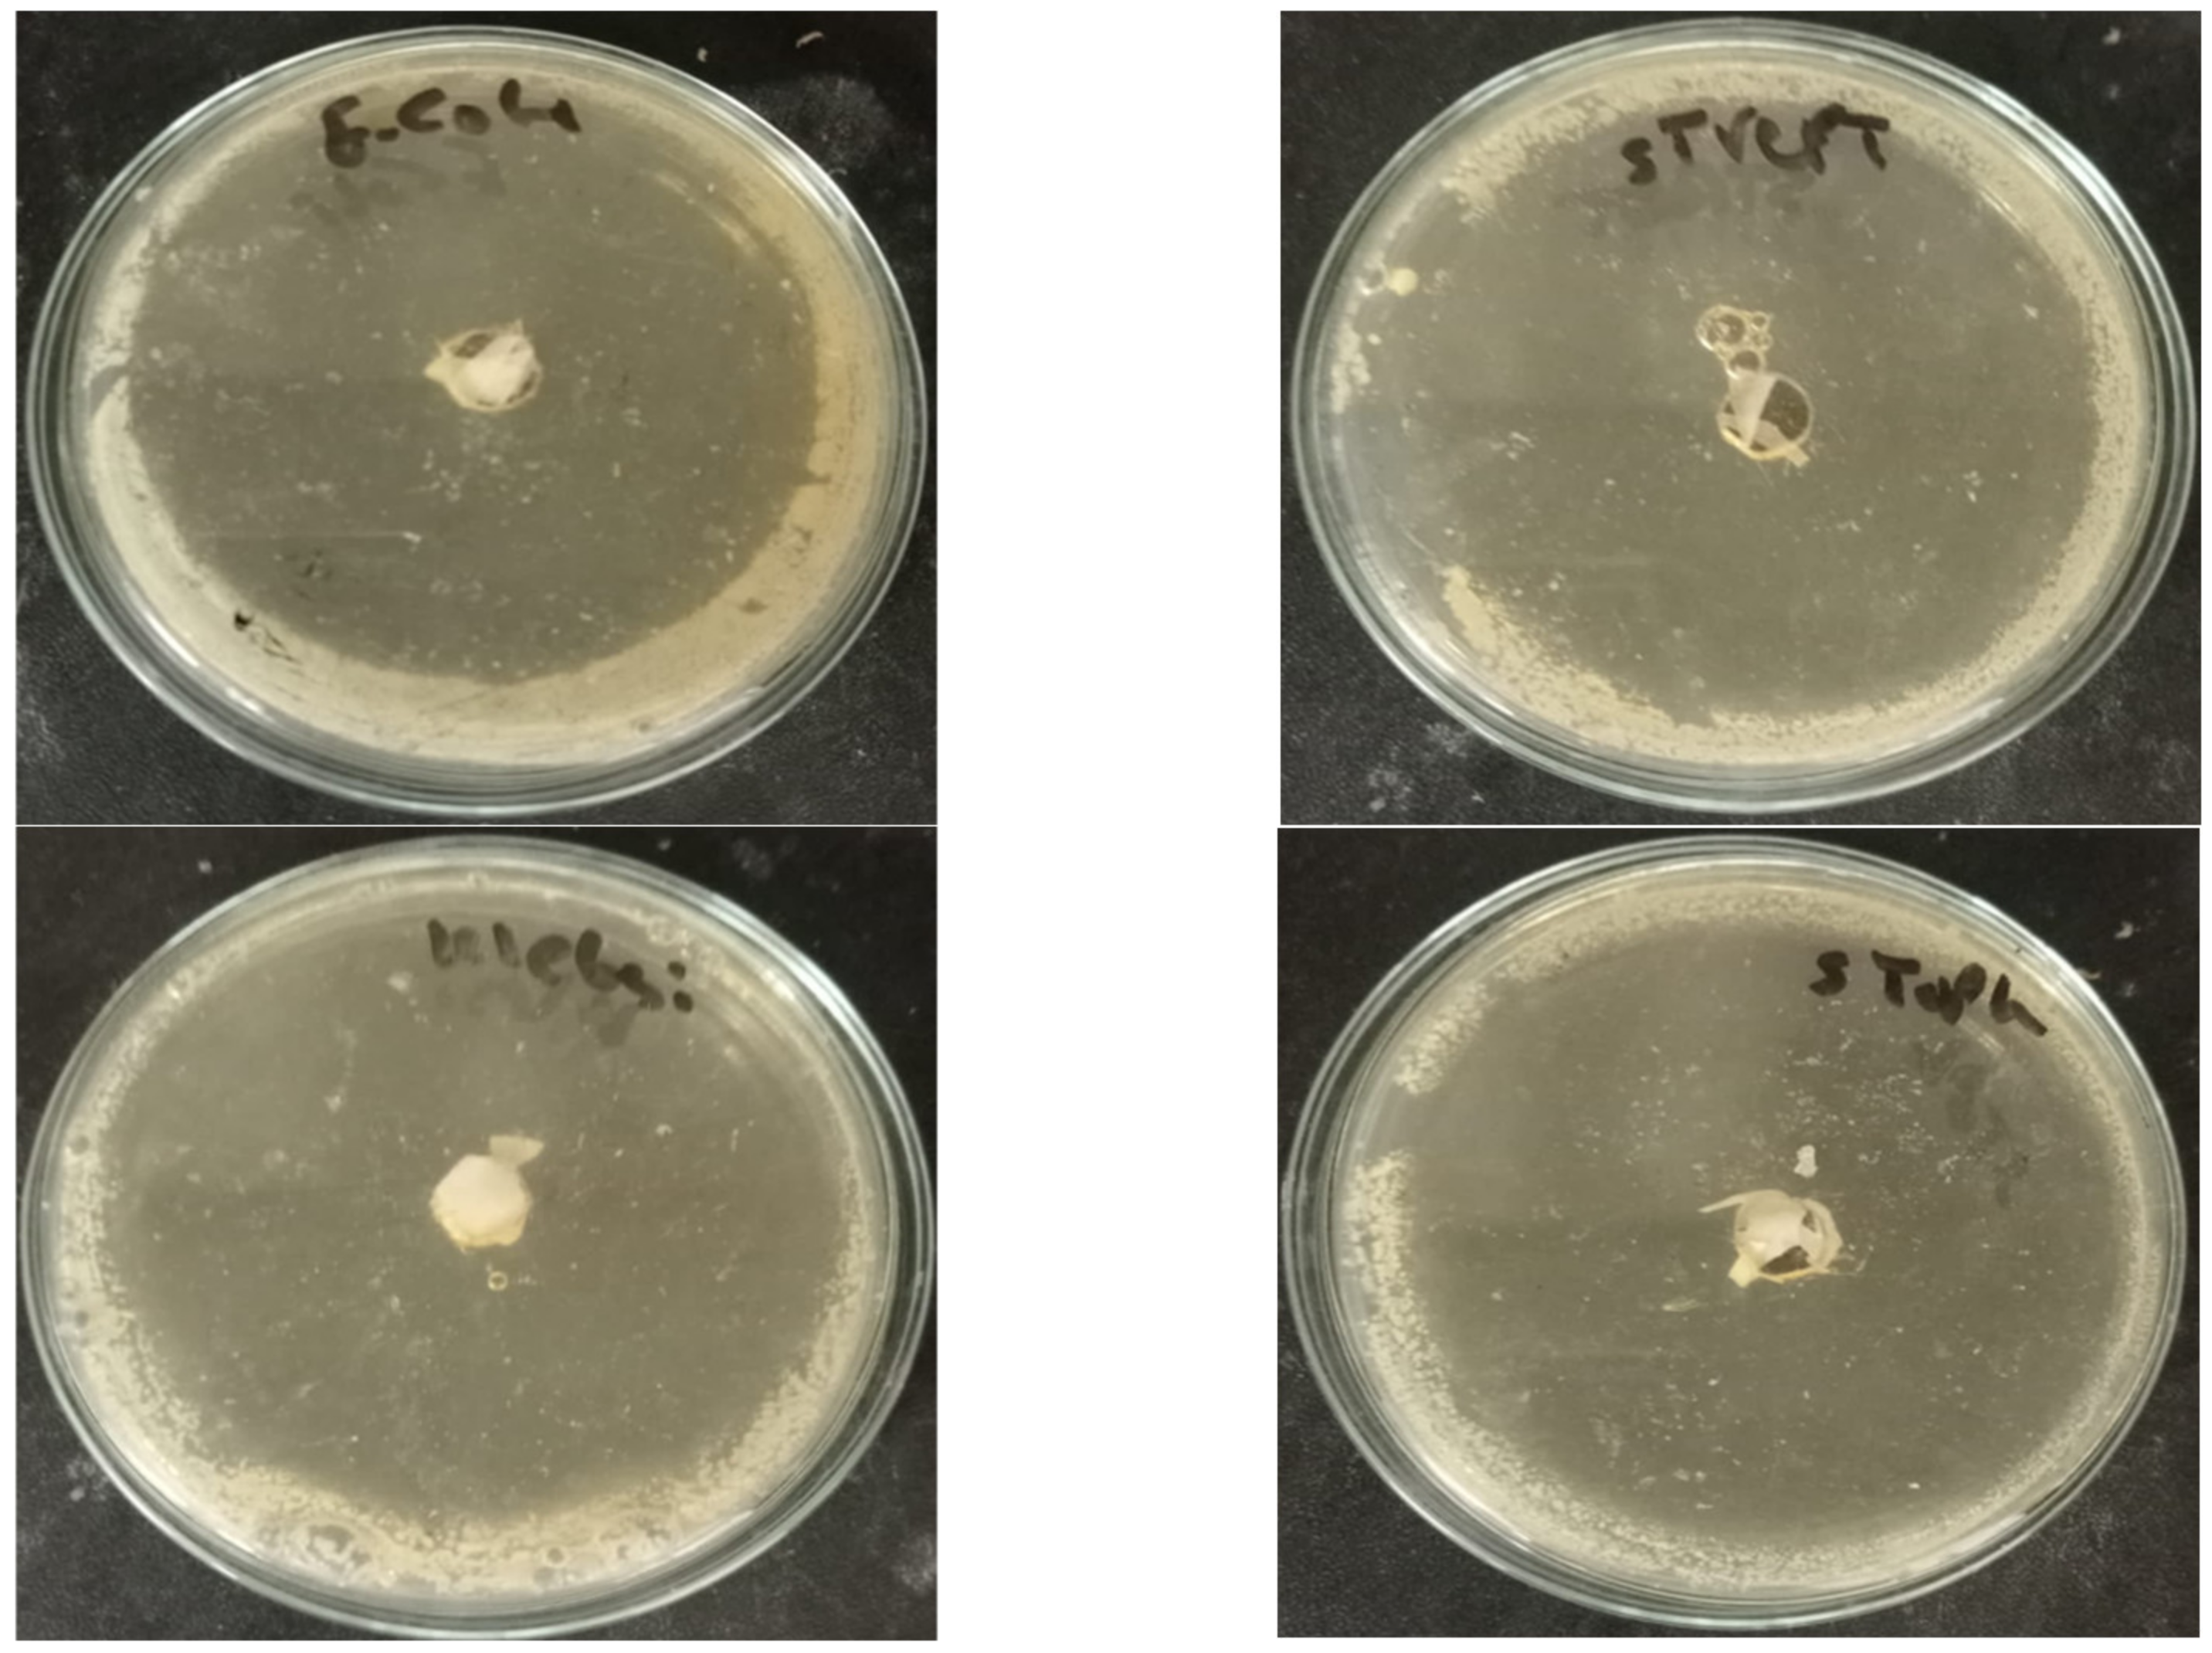

Bismuth Oxide Composite-Based Agricultural Waste for Wound Dressing Applications
Abstract
1. Introduction
2. Result and Discussion
2.1. Fourier-Transform Infrared Radiation Spectroscopy
2.2. X-ray Diffraction Analysis
2.3. Scanning Electron Microscopy (SEM)
2.4. Mechanical Properties
2.5. Antimicrobial Activity
2.6. Healing Test Method
2.7. In Vitro Cell Migration
3. Materials and Methods
3.1. Synthesis of Bismuth Oxide
3.2. Hand-Sheet Making
3.3. Preparation of Coating Solutions
3.4. Characterization of Papers
3.4.1. Fourier-Transform Infrared (FTIR) Spectroscopy
3.4.2. X-ray Diffraction Analysis
3.4.3. Scanning Electron Microscopy
3.4.4. Mechanical Properties
3.5. Antimicrobial Activity
3.6. Healing Test Method
3.6.1. Full-Thickness Wound Model Preparation
3.6.2. Preliminary Analysis of Wound Closure Rates
3.6.3. Histopathological Analysis
3.7. In Vitro Cell Migration
4. Conclusions
Author Contributions
Funding
Institutional Review Board Statement
Informed Consent Statement
Data Availability Statement
Conflicts of Interest
Sample Availability
References
- Shapiro, J.A. Bacteria as multicellular organisms. Sci. Am. 1988, 258, 82–89. [Google Scholar] [CrossRef]
- Bisen, P.; Debnath, M.; Prasad, G. Microbes: Concepts and Applications; Wiley: Hoboken, NJ, USA, 2012. [Google Scholar]
- Dwyer, L.R.; Scharschmidt, T.C. Early life host-microbe interactions in skin. Cell Host Microbe 2022, 30, 684–695. [Google Scholar] [CrossRef] [PubMed]
- Lutfi, S. Bacteria Effect on Health and Human-Review. Am. Int. J. Biol. Life Sci. 2019, 1, 23–27. [Google Scholar] [CrossRef]
- National Institutes of Health (U.S.); National Institute of Allergy and Infectious Diseases (U.S.). Understanding MICROBES in Sickness and in Health; U.S. Department of Health and Human Services, National Institutes of Health (NIH): Bethesda, MD, USA; National Institute of Allergy and Infectious Diseases: Rockville, MD, USA, 2006.
- Sood, A.; Granick, M.S.; Tomaselli, N.L. Wound dressings and comparative effectiveness data. Adv. Wound Care 2014, 3, 511–529. [Google Scholar] [CrossRef]
- Pokhrel, D.; Viraraghavan, T. Treatment of pulp and paper mill wastewater—A review. Sci. Total Environ. 2004, 333, 37–58. [Google Scholar] [CrossRef]
- Fahmy, Y.; Fahmy, T.; Mobarak, F.; El-Sakhawy, M.; Fadl, M.H. Agricultural Residues (Wastes) for Manufacture of Paper, Board, and Miscellaneous Products: Background Overview and Future Prospects. Int. J. ChemTech Res. 2017, 10, 424–448. [Google Scholar]
- Koul, B.; Yakoob, M.; Shah, M.P. Agricultural waste management strategies for environmental sustainability. Environ. Res. 2022, 206, 112285. [Google Scholar] [CrossRef]
- Sridach, W. Technology, The environmentally benign pulping process of non-wood fibers. Suranaree J. Sci. Technol. 2010, 17, 105–123. [Google Scholar]
- Ashori, A. Nonwood Fibers—A Potential Source of Raw Material in Papermaking. Polym. Plast. Technol. Eng. 2006, 45, 1133–1136. [Google Scholar] [CrossRef]
- Rainey, T.J.; Covey, G. Pulp and paper production from sugarcane bagasse. In Sugarcane-Based Biofuels and Bioproducts; John Wiley & Sons: Hoboken, NJ, USA, 2016; pp. 259–280. [Google Scholar]
- Novo, L.P.; Bras, J.; Belgacem, M.N.; Curvelo, A.A.D.S. Pulp and Paper from Sugarcane: Properties of Rind and Core Fractions. J. Renew. Mater. 2018, 6, 160–168. [Google Scholar] [CrossRef]
- Bell, K.; Cave, S. Comparison of environmental impact of plastic, paper and cloth bags. Res. Libr. Serv. Brief. Note 2011, 1–21. [Google Scholar]
- Jalil, M.A.; Mian, M.N.; Rahman, M.K. Using Plastic Bags and Its Damaging Impact on Environment and Agriculture; Macrothink Institute: Las Vegas, NV, USA, 2011. [Google Scholar]
- Whitesides, G.M. Nanoscience, Nanotechnology, and Chemistry. Small 2005, 1, 172–179. [Google Scholar] [CrossRef]
- Vijayakumar, M.D.; Surendhar, G.J.; Natrayan, L.; Patil, P.P.; Ram, P.M.B.; Paramasivam, P. Evolution and recent scenario of nanotechnology in agriculture and food industries. J. Nanomater. 2022, 2022, 1–17. [Google Scholar] [CrossRef]
- Singh, J.; Vishwakarma, K.; Ramawat, N.; Rai, P.; Singh, V.K.; Mishra, R.K.; Kumar, V.; Tripathi, D.K.; Sharma, S. Nanomaterials and microbes’ interactions: A contemporary overview. 3 Biotech 2019, 9, 68. [Google Scholar] [CrossRef]
- Chausali, N.; Saxena, J.; Prasad, R. Recent trends in nanotechnology applications of bio-based packaging. J. Agric. Food Res. 2022, 7, 100257. [Google Scholar] [CrossRef]
- Chenthamara, D.; Subramaniam, S.; Ramakrishnan, S.G.; Krishnaswamy, S.; Essa, M.M.; Lin, F.H.; Qoronfleh, M.W. Therapeutic efficacy of nanoparticles and routes of administration. Biomater. Res. 2019, 23, 1–29. [Google Scholar] [CrossRef]
- Gao, Y.; Anand, M.A.V.; Ramachandran, V.; Karthikkumar, V.; Shalini, V.; Vijayalakshmi, S.; Ernest, D. Biofabrication of zinc oxide nanoparticles from Aspergillus niger, their antioxidant, antimicrobial and anticancer activity. J. Clust. Sci. 2019, 30, 937–946. [Google Scholar] [CrossRef]
- Saravanakumar, K.; Mariadoss, A.V.A.; Sathiyaseelan, A.; Wang, M.-H. Synthesis and characterization of nano-chitosan capped gold nanoparticles with multifunctional bioactive properties. Int. J. Biol. Macromol. 2020, 165, 747–757. [Google Scholar] [CrossRef]
- Rabiee, N.; Ahmadi, S.; Akhavan, O.; Luque, R.J.M. Silver and gold nanoparticles for antimicrobial purposes against multi-drug resistance bacteria. Materials 2022, 15, 1799. [Google Scholar] [CrossRef]
- Vassallo, A.; Silletti, M.F.; Faraone, I.; Milella, L. Nanoparticulate antibiotic systems as antibacterial agents and antibiotic delivery platforms to fight infections. J. Nanomater. 2020, 2020, 6905631. [Google Scholar] [CrossRef]
- Qian, H.; Liu, J.; Wang, X.; Pei, W.; Fu, C.; Ma, M.; Huang, C. The state-of-the-art application of functional bacterial cellulose-based materials in biomedical fields. Carbohydr. Polym. 2023, 300, 120252. [Google Scholar] [CrossRef] [PubMed]
- Kumar, A.; Gullapalli, H.; Balakrishnan, K.; Botello-Mendez, A.; Vajtai, R.; Terrones, M.; Ajayan, P.M. Flexible ZnO–cellulose nanocomposite for multisource energy conversion. Small 2011, 7, 2173–2178. [Google Scholar] [CrossRef] [PubMed]
- Mahadeva, S.K.; Kim, J. Hybrid nanocomposite based on cellulose and tin oxide: Growth, structure, tensile and electrical characteristics. Sci. Technol. Adv. Mater. 2011, 12, 055006. [Google Scholar] [CrossRef] [PubMed]
- Siró, I.; Plackett, D. Microfibrillated cellulose and new nanocomposite materials: A review. Cellulose 2010, 17, 459–494. [Google Scholar] [CrossRef]
- Pinto, R.J.; Daina, S.; Sadocco, P.; Neto, C.P.; Trindade, T. Antibacterial activity of nanocomposites of copper and cellulose. BioMed Res. Int. 2013, 2013, 280512. [Google Scholar] [CrossRef]
- Sureshkumar, M.; Siswanto, D.Y.; Lee, C.-K. Magnetic antimicrobial nanocomposite based on bacterial cellulose and silver nanoparticles. J. Mater. Chem. 2010, 20, 6948–6955. [Google Scholar] [CrossRef]
- Bhushan, B.; Gupta, B.K. Handbook of Tribology: Materials, Coatings, and Surface Treatments; Krieger Pub. Co.: Malabar, FL, USA, 1991. [Google Scholar]
- Fotovvati, B.; Namdari, N.; Dehghanghadikolaei, A. On Coating Techniques for Surface Protection: A Review. J. Manuf. Mater. Process. 2019, 3, 28. [Google Scholar] [CrossRef]
- Dehghanghadikolaei1, A.; Mohammadian, B.; Namdari, N.; Fotovvati, B. Abrasive machining techniques for biomedical device applications. J. Mater. Sci. 2018, 5, 1–11. [Google Scholar]
- Li, J.; Wang, J.; Zhang, Z.; Pan, Y.; Jiang, Z.; Hu, Y.; Wang, L. Fucoidan-loaded, neutrophil membrane-coated nanoparticles facilitate MRSA-accompanied wound healing. Mater. Des. 2023, 227, 111758. [Google Scholar] [CrossRef]
- Hernandez-Delgadillo, R.; Velasco-Arias, D.; Martinez-Sanmiguel, J.J.; Diaz, D.; Zumeta-Dube, I.; Arevalo-Niño, K.; Cabral-Romero, C. Bismuth oxide aqueous colloidal nanoparticles inhibit Candida albicans growth and biofilm formation. Int. J. Nanomed. 2013, 8, 1645–1652. [Google Scholar]
- Qin, F.; Zhao, H.; Li, G.; Yang, H.; Li, J.; Wang, R.; Liu, Y.; Hu, J.; Sun, H.; Chen, R. Size-tunable fabrication of multifunctional Bi2O3 porous nanospheres for photocatalysis, bacteria inactivation and template-synthesis. Nanoscale 2014, 6, 5402–5409. [Google Scholar] [CrossRef]
- Liu, Q.; Li, J.; Zhong, X.; Dai, Z.; Lu, Z.; Yang, H.; Chen, R. Enhanced antibacterial activity and mechanism studies of Ag/Bi2O3 nanocomposites. Adv. Powder Technol. 2018, 29, 2082–2090. [Google Scholar] [CrossRef]
- Meng, X.; Lu, Y.; Gao, Y.; Cheng, S.; Tian, F.; Xiao, Y.; Li, F. Chitosan/alginate/hyaluronic acid polyelectrolyte composite sponges crosslinked with genipin for wound dressing application. Int. J. Biol. Macromol. 2021, 182, 512–523. [Google Scholar] [CrossRef]
- Hubner, P.; Donati, N.; Quines, L.K.D.M.; Tessaro, I.C.; Marcilio, N.R. Gelatin-based films containing clinoptilolite-Ag for application as wound dressing. Mater. Sci. Eng. C 2020, 107, 110215. [Google Scholar] [CrossRef]
- Finnie, A. Hydrocolloids in wound management: Pros and cons. Br. J. Community Nurs. 2002, 7, 338–345. [Google Scholar] [CrossRef]
- Shi, Y.; Zhou, M.; Zhao, S.; Li, H.; Wang, W.; Cheng, J.; Jin, L.; Wang, Y. Janus amphiphilic nanofiber membranes synergistically drive antibacterial and anti-inflammatory strategies for skin wound healing. Mater. Des. 2023, 227, 111778. [Google Scholar] [CrossRef]
- Francesko, A.; Petkova, P.; Tzanov, T. Hydrogel dressings for advanced wound management. Curr. Med. Chem. 2018, 25, 5782–5797. [Google Scholar] [CrossRef]
- Jiang, J.; Zhao, K.; Xiao, X.; Zhang, L. Synthesis and facet-dependent photoreactivity of BiOCl single-crystalline nanosheets. J. Am. Chem. Soc. 2012, 134, 4473–4476. [Google Scholar] [CrossRef]
- Nurmalasari, N.; Yulizar, Y.; Apriandanu, D.O.B. Bi2O3 nanoparticles: Synthesis, characterizations, and photocatalytic activity. IOP Conf. Ser. Mater. Sci. Eng. 2020, 763, 012036. [Google Scholar] [CrossRef]
- Adel, A.M.; Al-Shemy, M.T.; Diab, M.A.; El-Sakhawy, M.; Toro, R.G.; Montanari, R.; de Caro, T.; Caschera, D. Fabrication of packaging paper sheets decorated with alginate/oxidized nanocellulose-silver nanoparticles bio-nanocomposite. Int. J. Biol. Macromol. 2021, 181, 612–620. [Google Scholar] [CrossRef]
- Ahmed, N.M.; Adel, A.M.; Diab, M.A. Packaging paper with improved mechanical and oil absorption properties based on novel ingredients. Packag. Technol. Sci. 2020, 33, 303–320. [Google Scholar] [CrossRef]
- Kadla, J.; Gilbert, R.D. Cellulose structure: A review. Cellul. Chem. Technol. 2000, 34, 197–216. [Google Scholar]
- Wulandari, W.; Rochliadi, A.; Arcana, I.M. Nanocellulose prepared by acid hydrolysis of isolated cellulose from sugarcane bagasse. IOP Conf. Ser. Mater. Sci. Eng. 2016, 107, 012045. [Google Scholar] [CrossRef]
- Kumar, A.; Negi, Y.S.; Choudhary, V.; Bhardwaj, N. Characterization of Cellulose Nanocrystals Produced by Acid-Hydrolysis from Sugarcane Bagasse as Agro-Waste. J. Mater. Phys. Chem. 2014, 2, 1–8. [Google Scholar] [CrossRef]
- Ashour, A.; El-Batal, A.I.; Maksoud, M.A.; El-Sayyad, G.S.; Labib, S.; Abdeltwab, E.; El-Okr, M. Antimicrobial activity of metal-substituted cobalt ferrite nanoparticles synthesized by sol–gel technique. Particuology 2018, 40, 141–151. [Google Scholar] [CrossRef]
- Soliman, M.; Sadek, A.A.; Abdelhamid, H.N.; Hussein, K. Graphene oxide-cellulose nanocomposite accelerates skin wound healing. Res. Vet. Sci. 2021, 137, 262–273. [Google Scholar] [CrossRef]
- Silva, N.H.C.S.; Garrido-Pascual, P.; Moreirinha, C.; Almeida, A.; Palomares, T.; Alonso-Varona, A.; Vilela, C.; Freire, C.S.R. Multifunctional nanofibrous patches composed of nanocellulose and lysozyme nanofibers for cutaneous wound healing. Int. J. Biol. Macromol. 2020, 165, 1198–1210. [Google Scholar] [CrossRef]
- Kadaikunnan, S.; Rejiniemon, T.S.; Khaled, J.M.; Alharbi, N.S.; Mothana, R. In-vitro antibacterial, antifungal, antioxidant and functional properties of Bacillus amyloliquefaciens. Ann. Clin. Microbiol. Antimicrob. 2015, 14, 9. [Google Scholar] [CrossRef]
- Baker, C.N.; Stocker, S.A.; Culver, D.H.; Thornsberry, C. Comparison of the E Test to agar dilution, broth microdilution, and agar diffusion susceptibility testing techniques by using a special challenge set of bacteria. J. Clin. Microbiol. 1991, 29, 533–538. [Google Scholar] [CrossRef]
- Magaldi, S.; Mata-Essayag, S.; de Capriles, C.H.; Perez, C.; Colella, M.T.; Olaizola, C.; Ontiveros, Y. Well diffusion for antifungal susceptibility testing. Int. J. Infect. Dis. 2004, 8, 39–45. [Google Scholar] [CrossRef]
- Fayemi, O.E.; Ekennia, A.C.; Katata-Seru, L.; Ebokaiwe, A.P.; Ijomone, O.M.; Onwudiwe, D.C.; Ebenso, E.E. Antimicrobial and wound healing properties of Polyacrylonitrile-moringa extract nanofibers. ACS Omega 2018, 3, 4791–4797. [Google Scholar] [CrossRef]
- Banchroft, J.; Stevens, A.; Turner, D. Theory and Practice of Histological Techniques; Churchil Livingstone: London, UK, 1996. [Google Scholar]
- Liang, C.-C.; Park, A.Y.; Guan, J.-L. In vitro scratch assay: A convenient and inexpensive method for analysis of cell migration in vitro. Nat. Protoc. 2007, 2, 329–333. [Google Scholar] [CrossRef]

| Sample ID | Bulk Density (Kg/m3) | Maximum Load (N) | Breaking Length (m) | Elongation at Maximum Load (mm) | Stiffness (N/m) | Tensile Index (N·m/g) | Young’s Modulus (MPa) | |||||||
|---|---|---|---|---|---|---|---|---|---|---|---|---|---|---|
| Blank | 759.59 | 60.78 | 4.75 | 3.15 | 58.50 | 669.92 | 3545.17 | |||||||
| Blank alginate | 568.59 | −25.15 | 59.91 | −1.43 | 4.75 | 0.02 | 4.10 | 29.98 | 48.88 | −16.43 | 570.12 | −14.90 | 2962.67 | −16.43 |
| 25% Bi2O3 | 612.54 | −19.36 | 70.87 | 16.59 | 5.87 | 23.67 | 4.07 | 29.21 | 50.66 | −13.40 | 619.32 | −7.55 | 2597.78 | −26.72 |
| 50% Bi2O3 | 699.80 | −7.87 | 65.84 | 8.32 | 5.35 | 12.64 | 4.26 | 35.08 | 53.51 | −8.52 | 641.53 | −4.24 | 2854.04 | −19.50 |
| 75% Bi2O3 | 684.37 | −9.90 | 64.33 | 5.83 | 5.08 | 7.03 | 4.41 | 39.88 | 48.26 | −17.50 | 562.32 | −16.06 | 2474.69 | −30.20 |
| 100% Bi2O3 | 718.31 | −5.43 | 68.78 | 13.16 | 5.48 | 15.36 | 4.70 | 48.92 | 54.73 | −6.43 | 642.98 | −4.02 | 3040.80 | −14.23 |
| Pathogenic Strain | Inhibition Zone Diameter (mm) ** |
|---|---|
| Gram-negative bacteria | |
| Klebsiella pneumonia ATCC700603 | |
| Paper 25% | 30 |
| Paper 100% | 71 |
| Antibiotic (0.1%) | 38 |
| Escherichia coli ATCC25922 | |
| Paper 25% | 27 |
| Paper 100% | 67 |
| Antibiotic (0.1%) | 40 |
| Gram-positive bacteria | |
| Staphylococcus aureus ATCC25923 | |
| Paper 25% | 29 |
| Paper 100% | 68 |
| Antibiotic (0.1%) | 30 |
| Streptococcus pyogenes EMCC1772 | |
| Paper 25% | 25 |
| Paper 100% | 69 |
| Antibiotic (0.1%) | 28 |
| Days | Saline | Dermazine | Paper Coated with Bismuth Oxide | |||
|---|---|---|---|---|---|---|
| Area (cm2) | Closure % | Area (cm2) | Closure % | Area (cm2) | Closure % | |
| 0 | 9.39 ± 0.57 | Nil | 13.96 ± 0.77 | Nil | 19.07 ± 0.05 | Nil |
| 7 | 8.06 ± 0.62 | 14.21 | 3.31 ± 0.45 | 76.31 | 3.46 ± 0.15 | 81.86 |
| 14 | 5.80 ± 0.08 | 38.80 | 0.00 ± 0.00 | 100 | 0.00 ± 0.00 | 100 |
Disclaimer/Publisher’s Note: The statements, opinions and data contained in all publications are solely those of the individual author(s) and contributor(s) and not of MDPI and/or the editor(s). MDPI and/or the editor(s) disclaim responsibility for any injury to people or property resulting from any ideas, methods, instructions or products referred to in the content. |
© 2023 by the authors. Licensee MDPI, Basel, Switzerland. This article is an open access article distributed under the terms and conditions of the Creative Commons Attribution (CC BY) license (https://creativecommons.org/licenses/by/4.0/).
Share and Cite
Hassan, M.; Diab, M.A.; Abd El-Wahab, M.G.; Hegazi, A.H.; Emwas, A.-H.; Jaremko, M.; Hagar, M. Bismuth Oxide Composite-Based Agricultural Waste for Wound Dressing Applications. Molecules 2023, 28, 5900. https://doi.org/10.3390/molecules28155900
Hassan M, Diab MA, Abd El-Wahab MG, Hegazi AH, Emwas A-H, Jaremko M, Hagar M. Bismuth Oxide Composite-Based Agricultural Waste for Wound Dressing Applications. Molecules. 2023; 28(15):5900. https://doi.org/10.3390/molecules28155900
Chicago/Turabian StyleHassan, Mayar, Mohamed A. Diab, Miral G. Abd El-Wahab, Abdelrahman H. Hegazi, Abdul-Hamid Emwas, Mariusz Jaremko, and Mohamed Hagar. 2023. "Bismuth Oxide Composite-Based Agricultural Waste for Wound Dressing Applications" Molecules 28, no. 15: 5900. https://doi.org/10.3390/molecules28155900
APA StyleHassan, M., Diab, M. A., Abd El-Wahab, M. G., Hegazi, A. H., Emwas, A.-H., Jaremko, M., & Hagar, M. (2023). Bismuth Oxide Composite-Based Agricultural Waste for Wound Dressing Applications. Molecules, 28(15), 5900. https://doi.org/10.3390/molecules28155900

